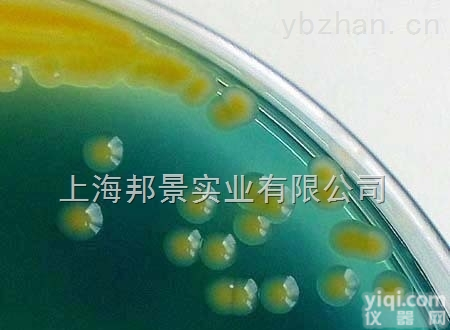
<em>加利福尼亚</em>拟<em>威尔</em><em>酵母</em>价格

加利福尼亚拟威尔酵母图片概念:
一,菌种的概念 原意是指孢子(相当于植物的种子) ,但在实际生产中,常将经过人工培养的纯菌丝体连同培养基质一同叫做菌种。
二,菌种的类型 在生产中根据菌种的来源,繁殖代数及生产目的,把菌种分为母种,原种和栽培种.分别叫一级种,二级种,三级种。母种:将纯菌丝体或孢子在试管培养基中繁殖而成.可以繁殖原种,也适宜菌种保藏.原种:母种菌丝在固体培养基上繁殖而成.这一过程增强菌丝对培养环境的适应性,又起到扩繁的作用.原种可以直接出菇。
中文名称
加利福尼亚拟威尔酵母图片属名 Williopsis
种名加词 californica
收藏时间 2008-4-30
原始编号 ATCC21356
模式菌株 非模式菌株
主要用途 a:3:{i:0;s:4:分类;i:1;s:4:研究;i:2;s:4:生产;}
特征特性 菌落乳白色,扁平,ZY略突起,边缘不整齐,短绒毛状,菌体椭圆或多边形,生长较快
具体用途
生物危害程度 四类
 加利福尼亚拟威尔酵母图片
加利福尼亚拟威尔酵母图片低温保存法:
1.简单保存法,将琼脂斜面孢子培养物、菌丝悬浮液以及由麸皮、大米、小米等谷物原料制成的孢子培养物置于4℃冰箱保存,保存时间不超过1~2个月,若将谷物原料制备的孢子瓶抽真空并在棉塞上浸蜡,以隔绝外界空气和水汽,保持时间可达3~4个月。
2.液氮超低温保存法,将生长稳定期的细胞悬浮在10%甘油或其他低冰点液体中,密封于安瓿管内,然后控制冷却速度,使安瓿管温度逐步下降至-35℃时,即可置于-150~-196℃的液氮罐中保存。大多数微生物如病毒、噬菌体、多种细菌、放线菌、酵母和原虫、特别是一些用冷冻干燥法有困难的微生物,都可用此法长期保存。
加利福尼亚拟威尔酵母图片菌株操作:
1、安瓿瓶开封:用浸过75%酒精的脱脂棉擦净安瓿管,用火焰加热其顶端,滴少量无菌水至加热顶端使之破裂,用锉刀或者镊子敲下已破裂的安瓿管顶端。
2、菌株恢复培养:用无菌吸管吸取0.3--0.5ml适宜的液体培养基,滴入安瓿管内,轻轻振荡,使冻干菌体溶解呈悬浮状。吸取全部菌体悬浮液,移植于1-2支建议的培养基试管中,并在建议的条件下培养。
3、注意事项:菌种活化前,请将安瓿管保存在6-10℃的环境下,某些菌种经过冷冻干燥保存后,延迟期较长,需要连续两次继代培养才能正常生长
4、复苏后的菌种在传1-2代后使用。
5、暂不启开的安瓿及复苏后需保藏的斜面应于4℃中保藏。
加利福尼亚拟威尔酵母图片操作流程:
菌株复苏:(按三区划线法将留菌管内的原始菌株进行复苏)
1) 所有菌株,显色培养基分4区,每区一株,标明菌株号、菌种名常用缩写如下:
cal: 白念珠菌 cgl:光滑念珠菌 cpa: 近平滑念珠菌 ctr: 热带念珠菌 ckr: 克柔念珠菌 cne: 新型隐球菌,其他菌种标记全名。
2) 隐球菌除传显色培养基以外,另传1/2块血平皿上述菌株统一37oC孵育48h
菌种鉴定:(48h后观察结果)。
Genistein M98462 446-72-0 HPLC≥98% 20mg/支
染料木苷 5,7-三羟异黄酮-7-糖苷 Genistin M98463 529-59-9 HPLC≥98% 20mg/支
欧前胡素 Imperatorin M98464 482-44-0 HPLC≥98% 20mg/支
异欧前胡素 Isoimperatorin M98465 482-45-1 HPLC≥98% 20mg/支
远志酸 Polygalacic acid M98466 22338-71-2 HPLC≥98% 20mg/支
远志皂苷元 Senegenin M98467 2469-34-3 HPLC≥98% 20mg/支
莱苞迪甙A 莱苞迪苷A Rebaudioside A M98468 58543-16-1 HPLC≥98% 10mg/支
黄芩苷 黄芩甙 Baicalin M98469 21967-41-9 HPLC≥98% 20mg/支
野黄芩苷 野黄芩甙;灯盏花乙素;灯盏花素 Scutellarin M98470 27740-01-8 HPLC≥98% 20mg/支
黄芩素 黄芩苷元; 黄芩黄素 Baicalein M98471 491-67-8 HPLC≥98% 20mg/支
秦皮素 秦皮亭;白蜡树内酯 Fraxetin M98472 574-84-5 HPLC≥98% 20mg/支
秦皮甲素 Esculin M98473 531-75-9 HPLC≥98% 20mg/支
秦皮乙素 6,7-Dihydroxycoumarin M98474 305-01-1 ≥98% 20mg/支
绿原酸 Chlorogenic acid M98475 327-97-9 HPLC≥98% 20mg/支
新绿原酸 5-咖啡酰奎宁酸 Neochlorogenic acid M98476 906-33-2 HPLC≥98% 20mg/支
隐绿原酸 4-咖啡酰奎宁酸 Cryptochlorogenic acid M98477 905-99-7 HPLC≥98% 20mg/支
异绿原酸A 3,5-二咖啡酰奎宁酸
rat Prostaglandin F,PG-F ELISA Kit 人抗肝肾微粒体抗体(LKM)ELISA Kit,48T/96T
rat Prostaglandin E1,PG-E1 ELISA Kit 人抗核周因子抗体(APF)ELISA Kit,48T/96T
rat Corticosterone,CORT ELISA Kit 人抗核抗体(ANA)ELISA Kit,48T/96T
rat Endothelin 1,ET-1 ELISA Kit 人抗环胍氨酸肽抗体(CCP)ELISA Kit,48T/96T
Rat bradykinin,BK ELISA Kit 人肾小球组织糖基化终末产物(GTE-AGE)ELISA Kit,48T/96T
rat Resistin ELISA Kit 人c-myc ELISA Kit,48T/96T
rat prolactin,PRL ELISA Kit 人c-fos ELISA Kit,48T/96T
rat growth hormone releasing hormone,GHRH ELISA Kit 人c-jun ELISA Kit,48T/96T
rat adrencocorticotropic hormone,ACTH ELISA Kit 人c-sis ELISA Kit,48T/96T
rat follicle-stimulating hormone,FSH ELISA Kit 人H-ras ELISA Kit,48T/96T
加利福尼亚拟威尔酵母图片rat Estradiol receptor,ER ELISA Kit 人抗眼肌抗体(EMAb)ELISA Kit,48T/96T
Rat Pro Atrial Natriuretic Peptide,Pro-ANP ELISA Kit 人抗肝特异性脂蛋白抗体(LSP)ELISA Kit,48T/96T
Rat Big Endothelin,Big ET ELISA Kit 人细胞绒毛蛋白/埃兹蛋白(cytovillin/ezrin)ELISA Kit,48T/96T
Rat very late appearing antigen,VLA ELISA Kit 人肾上腺素能a1A受体(ADRA1A)ELISA Kit,48T/96T
Rat Calcitonin,CT ELISA Kit 小鼠肾上腺素能a1A受体(ADRA1A)ELISA Kit,48T/96T
Rat Osteocalcin/Bone gla protein,OT/BGP ELISA Kit 大鼠肾上腺素能a1A受体(ADRA1A)ELISA Kit,48T/96T
加利福尼亚拟威尔酵母图片的优势是:
1.供货及时。我们订货周期短,运输时间短,在短时间内为您提供所需产品。
2.价格优惠:我公司是ScienCell和美国ATCC的ZG代理商,没有中间环节。在国内我们保证价格Z低。
3.服务保障:我们拥有专用的技术指导团队,对每售出的一件产品,提供全面的售前、售中和售后服务。
4.产品种类齐全:25个系统共150多种细胞,满足不同客户的要求。细胞经过严格的质控,纯度可达98%。常用产品备有现货。其产品类型如下:消化系统细胞株,呼吸系统细胞株,泌尿系统细胞株生殖系统细胞株 血液循环系统 内皮细胞细胞株 神经系统及其他细胞株,动物细胞株和菌
5.对于部分难培养的细胞我公司可代复苏细胞,并提供技术支持。
6.经验丰富:我公司是国内专业化的细胞销售公司,具有十余年细胞产品销售经验,有专业的销售团队和技术人员。